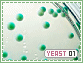

Collecting




























































































































































































































Keeping
















































































Random Keeps































Trading